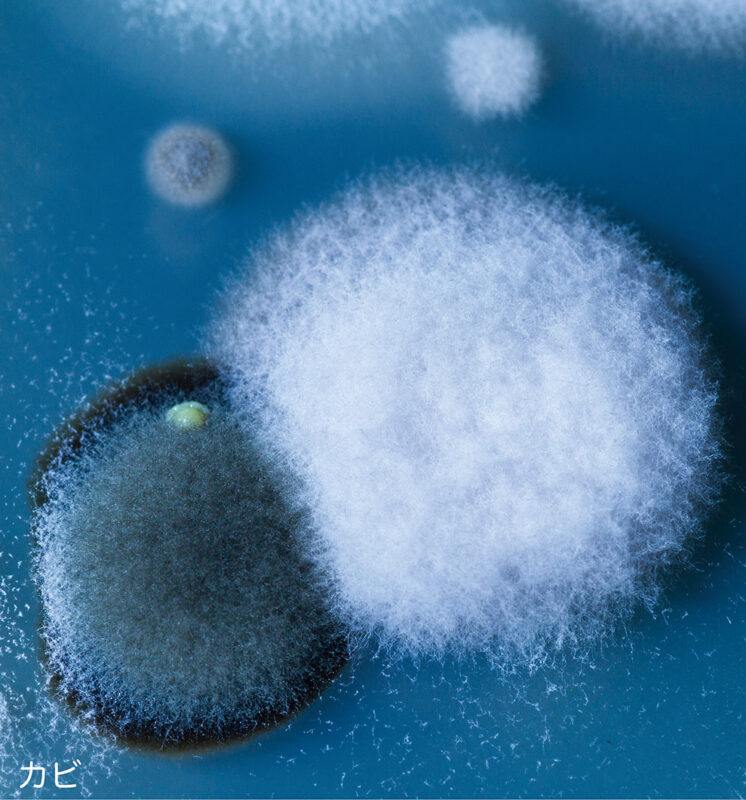

デザイン・造形学科 グラフィック・プロダクトデザインコース

作品仕様
作品解説
幼い頃から好きで続けてきた編み物や手芸において、その様々な手法が組み合わさった時の表現のおもしろさを探求した。手芸で表現されるものの多くが、花などの華やかできらびやかなものが多いため、あまり作品として目にしない菌類を選んで制作することで、自身の表現の幅を広げることを試みている。ひとつのモチーフの中にいくつかの手法と異なる素材を組み合わせた一方で、その違いがわかるように色は白で統一した。

キノコ、ミノムシ、カビ、参考モチーフ
センボンキツネノサカズキ、イモムシ、参考画像